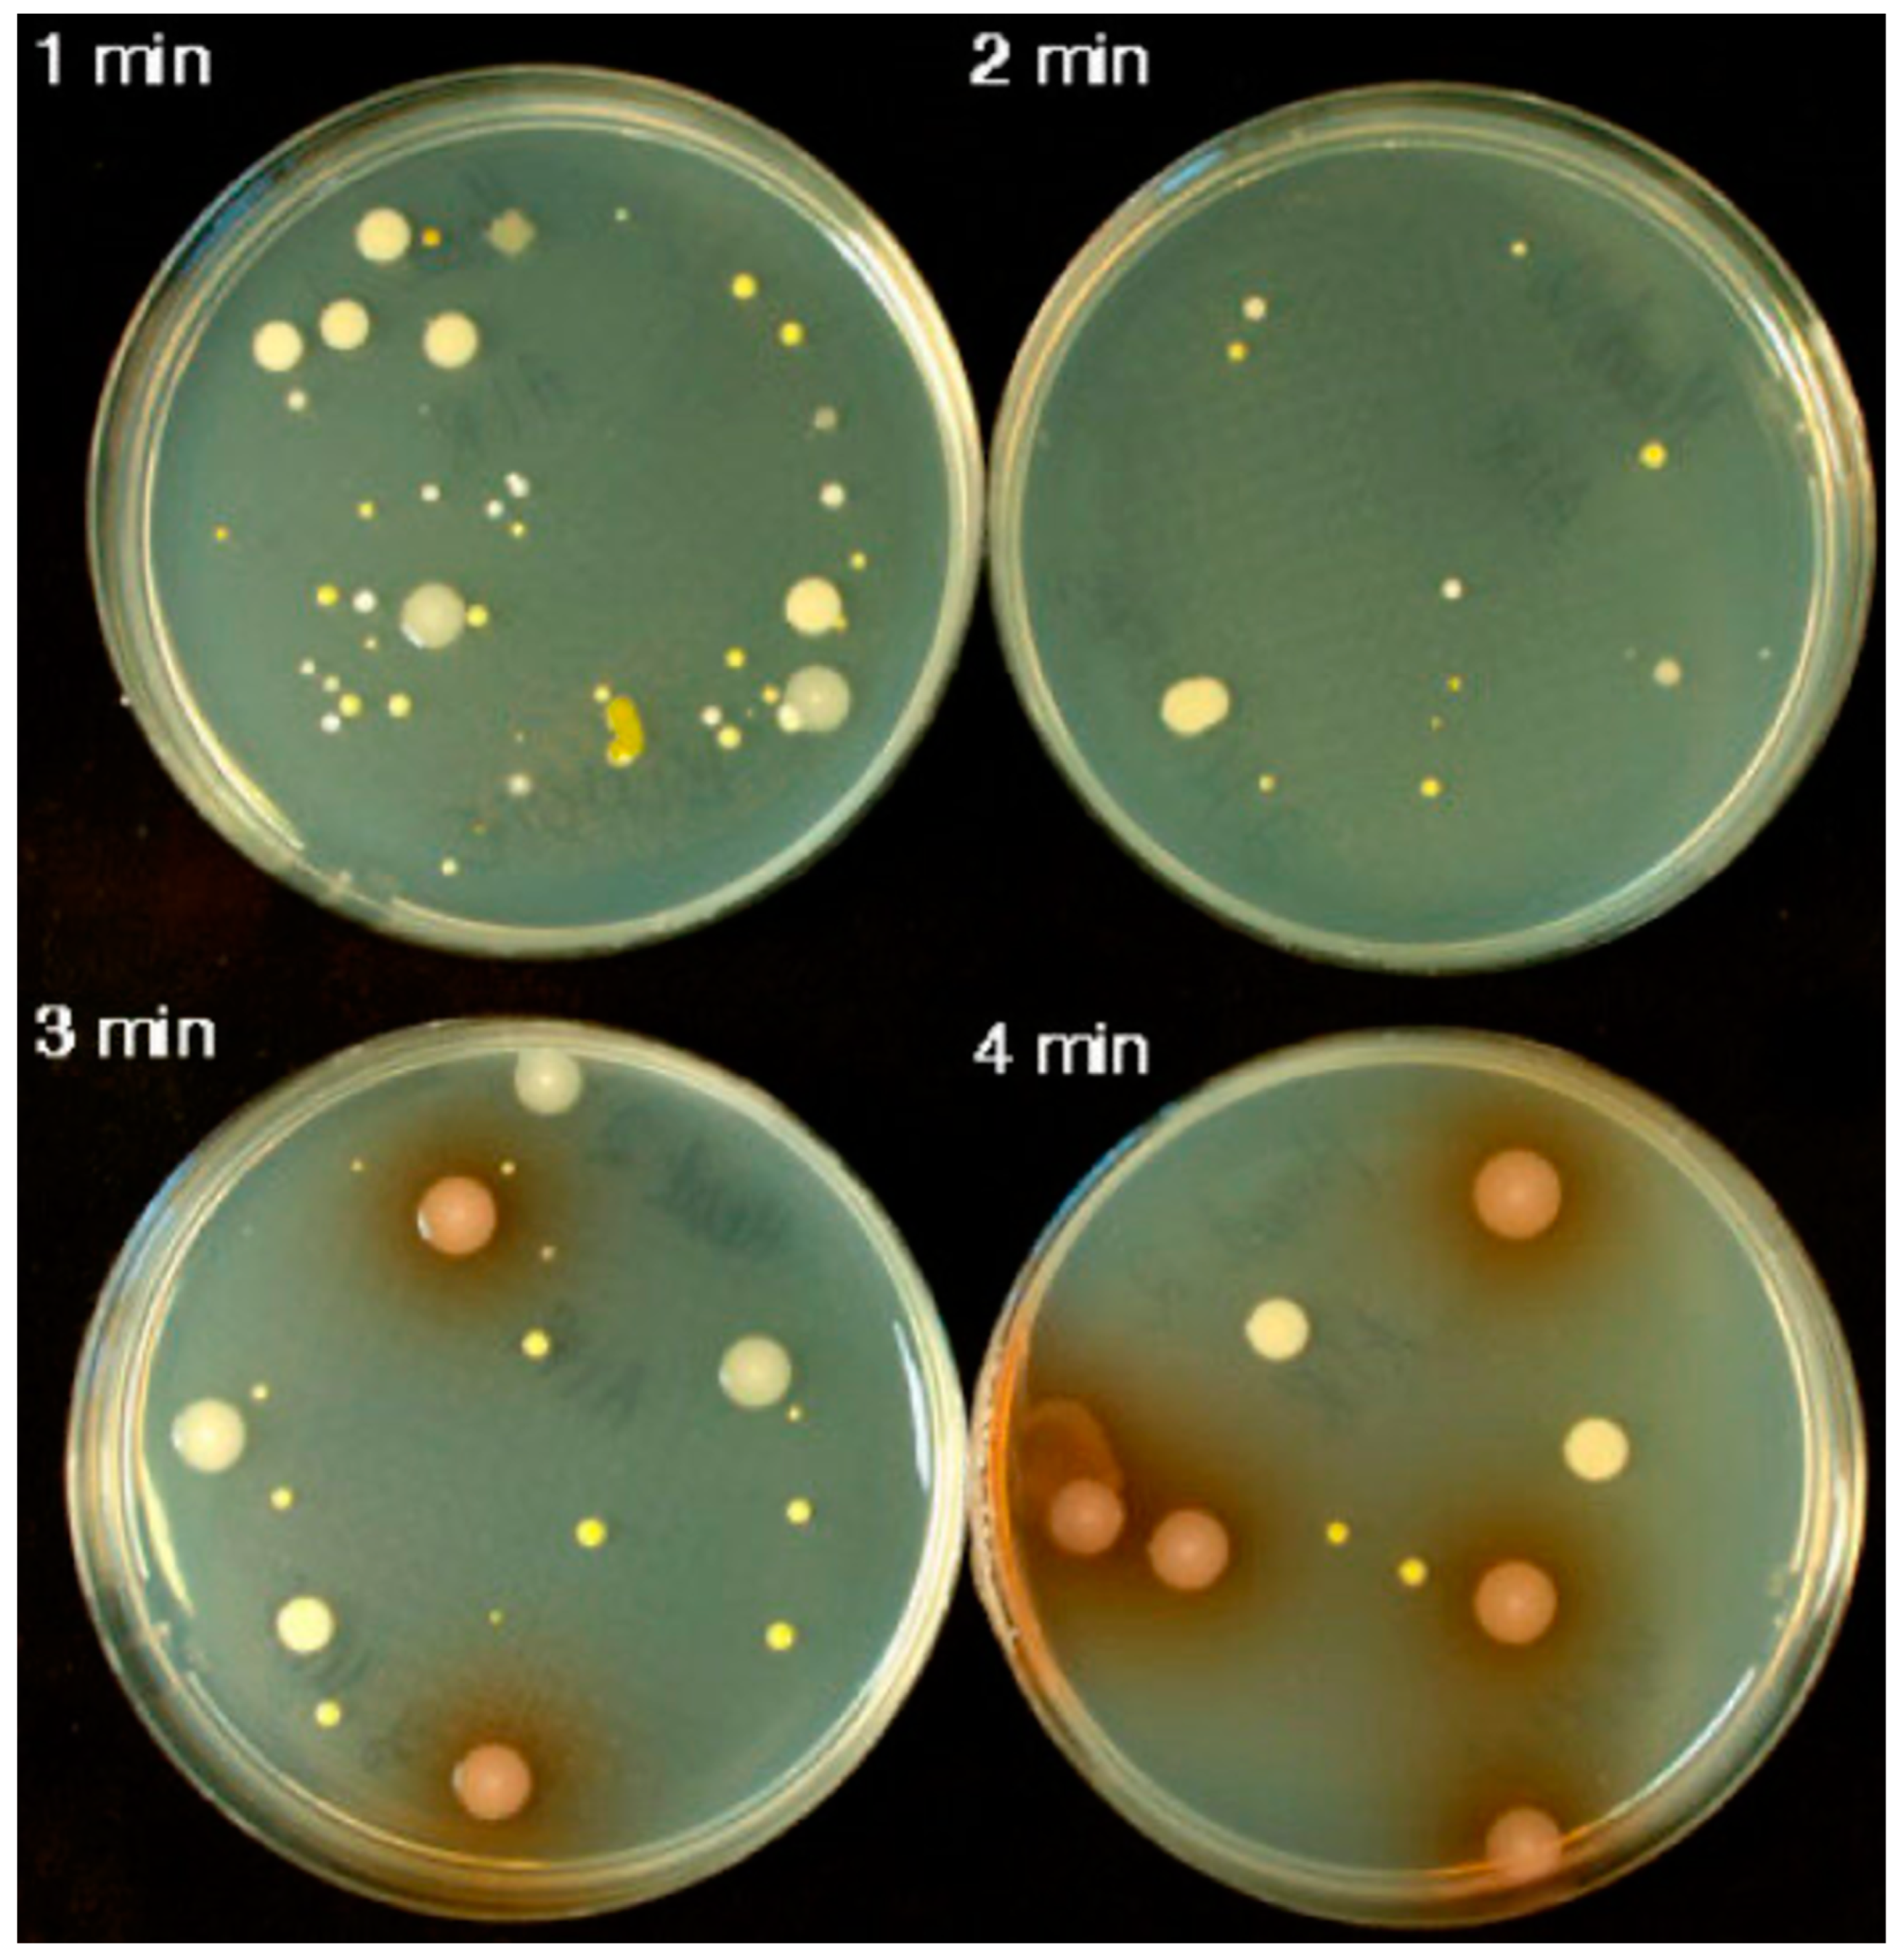
Hardware 03 00004 g001

Abstract
A novel temporally resolved settle-plate air sampler was developed using 3D printing technology to improve upon traditional passive air sampling methods. Conventional settle plates provide cumulative measurements of particle or microbial loads over an entire sampling period, lacking the temporal resolution necessary to identify specific contamination events. The described device integrates a petri plate within a 3D-printed housing featuring a narrow slit that exposes only a small portion of the plate to incoming particles. A rotary mechanism, driven by a mechanical clock motor, rotates the petri plate over 12 h, allowing for time-segmented sampling. Validation experiments demonstrated the device’s ability to accurately encode the temporal history of particle deposition using both aerosolized dyes and viable microbial spores. The device effectively correlated bioaerosol deposition with ambient wind conditions during outdoor sampling. The system is inexpensive (under USD 10), requires no specialized skills to assemble, and is compatible with existing settle plate methodologies. This innovation enhances the ability to conduct air quality assessments in critical environments, enabling data-driven decisions to mitigate contamination risks.
1. Introduction
The passive sampling of air is frequently accomplished by the use of settle-plate air samplers (a.k.a sedimentation plates), which are placed within environments to sample the particle pollution or microbial load. Settle plates rely on the gravitational sedimentation and/or impaction to provide a flux of particles to an otherwise clean and sterile sampling surface. Devices are frequently (and conveniently) fabricated from petri plates filled with proper growth agar as shown in Figure 1. This arrangement allows bioaerosols to grow into visible colonies for further characterization.
Settle plates are frequently used to assess contamination in critical environments such as clean rooms, operating rooms, hospitals, pharmaceutical manufacturing, cosmetics manufacturing, laboratories, and dental offices [1,2,3,4,5,6,7,8,9,10,11,12,13,14]. Settle plates are popular since they are commercially available, require no special equipment to operate, and are inexpensive (generally at a cost of USD 3–12 per plate) [15]. One caveat to conventional settle plates is the lack of ability for time-resolved measurement. Conventional settle plates integrate particle or microorganism load over the entire sampling period. There is little ability to ascertain what specific periods of time air quality was particularly poor. This handicaps the ability of researchers to determine what specific practices may be responsible for contaminating workspaces to make data-driven behavioral interventions.
In this short communication, a design for a temporally resolved settle plate air sampler is introduced. The device requires no special skills to assemble and is inexpensive at under USD 10. The device itself maintains the use of petri plates and is largely compatible with existing practices. However, a housing is constructed using a 3D printer which assures only a small portion of the plate is exposed to accumulate sample at a given instant. A rotary mechanism is used to rotate the petri plate 360 degrees over 12 h, allowing temporally resolved sampling to occur.
Figure 1.
Settle-plate air sampling of Pseudomonas aeruginosa. Reproduced from Bowling et al., Journal of Foot and Ankle Research, 2(1), 2009, DOI:10.1186/1757-1146-2-13 under CC BY 4.0 [16].
Figure 1.
Settle-plate air sampling of Pseudomonas aeruginosa. Reproduced from Bowling et al., Journal of Foot and Ankle Research, 2(1), 2009, DOI:10.1186/1757-1146-2-13 under CC BY 4.0 [16].
2. Design
The design criteria were guided by the desire to make the device inexpensive, accessible, and simple to fabricate and use. Figure 2 illustrates the basic design for the temporally resolved settle plate device. The basic idea is to house a petri plate within a chamber that restricts the active deposition area of the petri plate to a narrow slit. Particles with high deposition velocity which fall through this slit (2.7 × 18 mm, area = 49 mm2) will deposit on the sampling plate directly below the slit. If the petri dish (but not the slit) is rotated through 360 degrees at a fixed rate of rotation, the active sampling area will change over time. If the rotation rate is correlated to the time after the start of sampling, the particles impacting the petri plate at any instant will encode a historical record of particles present in air over the sampling interval. Through analysis of material deposited in a circular pattern around the plate, the analyst can reconstruct the temporal history of contamination within the airspace. This is not possible with traditional settle plate designs which integrate over a fixed period-of-time. Subsequently, the analyst has no ability to discern when a particle was deposited onto the plate’s surface. The design described within this report offers a technical advantage since temporal data is encoded within the sampling event. However, if material entering the slit is volatile or has low deposition velocity, it may spread throughout the sampler leading to undesirable results.
Figure 2.
Temporally resolved settle-plate air sampler. The petri plate cover is rotated by the hour dial from a clock mechanism. Particles deposit through the slit in the cover.
3. Build Instructions
The housing for petri plates was 3D printed from black ABS filament at estimated cost of <USD 1 for the required material. Plans for 3D printing of the housing are included in the Supplementary Files for this article. These plans are compatible with a large variety of 3D printers and print materials. Three parts are specified: the housing base (case.stl), the housing cover (cover.stl), and an insert to hold the rotating clock motor housing (mount.stl). All three parts are fabricated prior to proceeding.
An inexpensive mechanical clock (“Bernhard Products 10” non ticking wall clock) was acquired from Amazon.com for USD 6.89 and subsequently disassembled to extract the motor which rotates the dials. The aluminum dial for the hour hand was retained in place, but all other dials and components to the clock were removed and disposed of. Next, the cover to a standard 9 cm petri plate was affixed to the hour hand with adhesive (JB Weld). The center of the circle ascribed by the petri plate cover was coincident with the axis of rotation of the clock mechanism. The test version used JB Weld adhesive, but other options are likely to be just as effective. After the adhesive cured, a battery was installed, and rotation of the petri plate was confirmed visually.
Next, the motor housing mount was slid into the base and the clock motor installed into the mount. The motor was not glued in place but remains in place solely by gravity in the prototype. A suitable petri plate is then placed within the larger diameter cover and the device cover installed. The temporally resolved air sampler is now assembled and ready for use.
4. Operating Instructions
Since documenting the time at which a particle is deposited onto the plate provides valuable information, a circular time gauge has been developed for insertion into the sampling petri plate prior to beginning the experiment. A PDF file users may print in support of their experiments is provided in supplementary information. To use the printout, simply cut along the outer circular diameter of the clock face printed on the paper and insert the cutout into the petri dish prior to sampling. When beginning an air sampling experiment, the user aligns and installs the slit on the cover with the 0 h mark on the printout. At the conclusion of a 12 h sampling run, the gauge is read in hours from the start of the sampling period.
5. Validation
The temporally resolved settle plate sampler was tested for function by installing a printed clock face within the petri plate and aligning the entrance slit of the cover with the 0 h mark. Then, a light absorbing solution (nigrosin in water) was aerosolized (sprayed) with the aid of an airbrush above the entrance slit of the sampler at t = 30, 90, 150, 210, 280 min after starting the experiment. Figure 3A reports the result of this experiment. As observed, dark (black) deposits of sprayed aerosol have impacted onto the clock face printout at precisely the times when the aerosol was applied.
Figure 3.
(A) Nigrosin aerosol (spray) sampled at t = 30, 90, 150, 210, and 280 min after starting the experiment. (B) Aerosolized Saccharomyces cerevisiae spores sampled onto a petri plate with agar. Spores were applied ~30 s at t = 60, 120, 240, and 430 min after starting sampling. (C) Report of colony counts vs. segment of sampling hour (data from (B)). Colony counts were highest when applied, however, growth appears over an arc sub-tended by approx. 1 h. In both (A,B), aerosol was collected at room temperature (20 °C) and pressure (0.99 atm) with relative humidity of 50%.
Further, Figure 3B illustrates viable air sampling using the device. In this experiment, yeast was dispersed in water and aerosolized above the inlet to the sampler at fixed points in time. Again, an artist’s air brush was used to aerosolize the mixture. An agar filled petri plate was placed into the sampler. Aerosolized Saccharomyces cerevisiae spores were sampled onto the petri plate with agar. Spores were applied for approximately 30 s at t = 60, 120, 240, and 430 min after starting sampling. After incubating the plate at 35 °C for 48 h the presence of yeast growth on the agar was noted and documented with a photograph (Figure 3B). The number of colonies present within an arc subtended by a 1 h period centered on the hour marker was counted visually. Any colonies too small to be visually perceived were not counted. Figure 3C reports the colonies counted over time during this single experiment. As observed, colony density was highest during the specified periods of aerosolization. However, colonies deposited onto the agar in a relatively wide spatial region, sub-tending approx. 1 h. This effect limits the temporal resolution of the current design to roughly 1 h.
Figure 4 illustrates the results of one ambient air sampling experiment conducted at Amarillo Texas, USA during the evening of 4 March 2025 from 4:30 PM to 5 March at 4:30 AM local time. As observed, a significant quantity of colonies were recovered on the petri dish. Many colonies appear between 0 and 2 h, a period corresponding to very high winds at the sampling location. Conversely, the early morning hours of 5 March (hours 8–11) had only a light breeze present, and colony counts appear lower during this period. Figure 4B formalizes the relationship between colonies counted and local wind speed. The figure reports a general trend of higher colony counts depositing during windy periods.
Figure 4.
(A) Petri plate recovered after ambient air sampling outdoors from 4 March at 4:30 PM to 5 March at 4:30 AM local time. Wind conditions are reported. (B) Plot of colonies observed in each hourly segment vs. average hourly wind conditions reported in Amarillo, TX, USA.
6. Conclusions
A housing to enable a temporally resolved settle plate air sampler is described. The device can be produced for under USD 10 by investigators with access to a 3D printer. Using the hour dial of a mechanical clock and a petri plate allowed for the reconstruction of relative viable aerosol loading in time with approximately 1 h temporal resolution. It is envisioned that the device aids investigations of particle or microbial contamination in mission critical environments.
Supplementary Materials
The following supporting information can be downloaded at: https://www.mdpi.com/article/10.3390/hardware3020004/s1, File S1: case.stl; File S2: cover.stl; File S3: mount.stl; File S4: clockwheel.pdf.
| Name | Type | Description |
| S1 | .stl file | 3d print design file |
| S2 | .stl file | 3d print design file |
| S3 | .stl file | 3d print design file |
| S4 | .pdf file | Clock wheel insert to print |
Funding
This research received no external funding.
Institutional Review Board Statement
Not applicable.
Informed Consent Statement
Not applicable.
Data Availability Statement
Data is contained within the article or Supplementary Material.
Conflicts of Interest
The author declares no conflict of interest.
References
- Mainelis, G. Bioaerosol Sampling: Classical Approaches, Advances, and Perspectives. Aerosol Sci. Technol. 2020, 54, 496–519. [Google Scholar] [CrossRef] [PubMed]
- Datsugwai Mohammed, S.S.; Balogu, T.V. Sampling Methods for Airborne Microorganisms. In Aeromicrobiology; Elsevier: Amsterdam, The Netherlands, 2023; pp. 89–116. ISBN 9780323961226. [Google Scholar]
- Manibusan, S.; Mainelis, G. Passive Bioaerosol Samplers: A Complementary Tool for Bioaerosol Research. A Review. J. Aerosol Sci. 2022, 163, 105992. [Google Scholar] [CrossRef] [PubMed]
- Asefa, D.T.; Langsrud, S.; Gjerde, R.O.; Kure, C.F.; Sidhu, M.S.; Nesbakken, T.; Skaar, I. The Performance of SAS-Super-180 Air Sampler and Settle Plates for Assessing Viable Fungal Particles in the Air of Dry-Cured Meat Production Facility. Food Control 2009, 20, 997–1001. [Google Scholar] [CrossRef]
- Klees, A.G.; Ancrum, T. Environmental Monitoring Equipment: The Latest In Cleanrooms & Isolator Technologies. Contract Pharma, 9 October 2012. [Google Scholar]
- Setlhare, G.; Malebo, N.; Shale, K.; Lues, R. Identification of Airborne Microbiota in Selected Areas in a Health-Care Setting in South Africa. BMC Microbiol. 2014, 14, 100. [Google Scholar] [CrossRef] [PubMed]
- Bali, R.; Sharma, P.; Nagrath, S.; Gupta, P. Microbial Isolations from Maxillofacial Operation Theatre and Its Correlation to Fumigation in a Teaching Hospital in India. J. Maxillofac. Oral Surg. 2014, 13, 128–132. [Google Scholar] [CrossRef] [PubMed]
- Sandle, T. Real-Time Biological Particle Counting in Environmental Monitoring. Eur. Pharm. Rev. 2015, 20, 39–42. [Google Scholar]
- Whyte, W.; Eaton, T. Deposition Velocities of Airborne Microbecarrying Particles. Eur. J. Parenter. Pharm. Sci. 2016, 21, 45–49. [Google Scholar]
- Taaffe, K.; Lee, B.; Ferrand, Y.; Fredendall, L.; San, D.; Salgado, C.; Shvorin, D.; Khoshkenar, A.; Reeves, S. The Influence of Traffic, Area Location, and Other Factors on Operating Room Microbial Load. Infect. Control Hosp. Epidemiol. 2018, 39, 391–397. [Google Scholar] [CrossRef]
- Cobb, J. An Innovative Active Air Sampler for Continuous Viable Air Monitoring with Minimal Plate Changes. Clean Air Contain. Rev. 2020, 2020, 16–21. [Google Scholar]
- Adams, C.E.; Dancer, S.J. Dynamic Transmission of Staphylococcus Aureus in the Intensive Care Unit. Int. J. Environ. Res. Public Health 2020, 17, 2109. [Google Scholar] [CrossRef] [PubMed]
- Tan, K.S.; Chew, R.J.J.; Allen, P.F.; Yu, V.S.H. Aerosol-Generating Dental Procedures: A Reappraisal of Analysis Methods and Infection Control Measures. J. Hosp. Infect. 2021, 117, 81–88. [Google Scholar] [CrossRef] [PubMed]
- Dalmaso, G.; Campanella, A.; Lazzeri, P. Continuous and Effective Microbiological Air Monitoring in Critical Environments: A Comparison of Analytical Methodologies. PDA J. Pharm. Sci. Technol. 2020, 74, 446–455. [Google Scholar] [CrossRef] [PubMed]
- Settle Plates for Active and Passive Air Monitoring. Available online: https://www.sigmaaldrich.com/US/en/technical-documents/technical-article/microbiological-testing/viable-air-monitoring/settle-plates (accessed on 23 February 2025).
- Bowling, F.L.; Stickings, D.S.; Edwards-Jones, V.; Armstrong, D.G.; Boulton, A.J.M. Hydrodebridement of Wounds: Effectiveness in Reducing Wound Bacterial Contamination and Potential for Air Bacterial Contamination. J. Foot Ankle Res. 2009, 2, 13. [Google Scholar] [CrossRef] [PubMed]
Disclaimer/Publisher’s Note: The statements, opinions and data contained in all publications are solely those of the individual author(s) and contributor(s) and not of MDPI and/or the editor(s). MDPI and/or the editor(s) disclaim responsibility for any injury to people or property resulting from any ideas, methods, instructions or products referred to in the content. |
© 2025 by the author. Licensee MDPI, Basel, Switzerland. This article is an open access article distributed under the terms and conditions of the Creative Commons Attribution (CC BY) license (https://creativecommons.org/licenses/by/4.0/).


